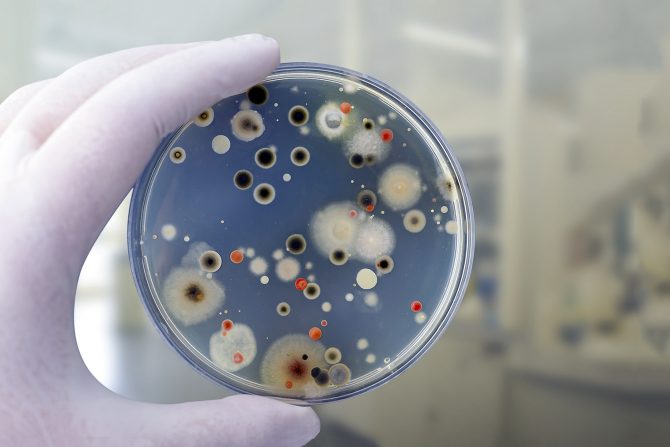
novi lek bakterije

Novi lek može biti efikasan protiv nekoliko stotina bakterija otpornih na antibiotike
Bakterijska antimikrobna rezistencija nastaje kada bakterije mutiraju tokom vremena i više ne reaguju na antibiotike, što otežava lečenje infekcija i povećava rizik od širenja bolesti i smrti
Novi lek može biti efikasan protiv nekoliko stotina bakterija otpornih na antibiotike, što bi mogli da doprinese efikasnijem lečenju obolelih i smanjenu smrtnosti, pokazalo je najnovije istraživanje.
Gram-pozitivne i gram-negativne bakterije
Bakterijska antimikrobna rezistencija (AMR) nastaje kada bakterije mutiraju tokom vremena i više ne reaguju na antibiotike, što otežava lečenje infekcija i povećava rizik od širenja bolesti . Naučnici su opisali infekcije uzrokovane bakterijama otpornim na antibiotike kao pretnju modernom zdravstvu.
Bakterije se mogu kategorisati kao gram-pozitivne ili gram-negativne na osnovu strukture njihovih ćelijskih membrana
Danski bakteriolog Hans Kristijan Gram 1884. godine razvio je test za razlikovanje bakterija na osnovu hemijskog i fizičkog sastava njihovih ćelijskih zidova. Gram je otkrio da neke bakterije imaju tanak ćelijski zid peptidoglikana. Ove bakterije su kategorisane kao gram-negativne, a njihova ćelijska struktura sprečava molekule antibiotika da uđu i akumuliraju se u ćeliji. Za razliku od njih, gram-pozitivnim bakterijama nedostaje spoljni sloj, ali su okružene debelim slojevima peptidoglikana nalik mrežici.
Zbog strukturne razlike ćelije, gram-negativne bakterije, kao što su pneumonija, infekcije urinarnog trakta (UTI) i infekcije krvotoka, teže se leče u poređenju sa onima koje izazivaju gram-pozitivne bakterije.
Novi potencijalni lek i potrebe za njim
Svetska zdravstvena organizacija (SZO) je 2017. godine identifikovala listu prioritetnih patogena otpornih na antibiotike koji predstavljaju "veliku pretnju po ljudsko zdravlje". Agencija je istakla hitnost potrebe za novim antibioticima. Većina patogena koje je navela SZO su gram-negativne bakterije.
Gram-negativne bakterije takođe uključuju četiri od šest najsmrtonosnijih patogena otpornih na lekove
Dr. Paul J. Hergenrother, profesor hemije na Univerzitetu u Ilinoisu, i njegov tim istraživača, nastojali su da stvore antibiotik koji bi se uspešno akumulirao u gram-negativnim ćelijama.
Dr Hergenrother i njegov tim odlučili su da ciljaju enzim FabI, koji je odgovoran za katalizaciju koraka koji određuje brzinu u biosintezi bakterijske masne kiseline. Pre ove studije, upotreba enzima FabI kao mete antibiotika bila je iskorišćena samo kod gram-pozitivnih infekcija. Rezultati ove studije objavljeni su u ACS Central Science.
Fabimicin i bakterije otporne na lekove
Istraživači su shvatili da fizičko-hemijske osobine malih molekula utiču na njihovu sposobnost da prodiru i akumuliraju unutar gram-negativnih bakterijskih ćelija. Ovo novo saznanje je obuhvaćeno novim smernicama za dizajn gram-negativnih penetrantnih jedinjenja.
Tim dr Hergenrothera počeo je sa Debio-1452, FabI inhibitorom koji je veoma moćan protiv gram-pozitivnog Staphilococcus aureus. Vođeni pravilima eNTRi, istraživači su napravili strukturne modifikacije molekula Debio-1452 sa ciljem stvaranja novog molekula koji je zadržao FabI inhibicionu moć Debio-1452, ali je takođe posedovao aktivnost protiv gram-negativnih bakterija.
Od skupa novosintetizovanih kandidata za lek Debio-1452, jedan molekul, pokazao je superiornu moć u početnim testovima.
Kliničko ispitivanje izolata
Nakon što su identifikovali fabimicin kao najperspektivnijeg kandidata za gram-negativne antibiotike, istraživači su procenili antibakterijsku aktivnost fabimicina u odnosu na panel gram-negativnih kliničkih izolata otpornih na više lekova.
Otkrili su da fabimicin ima impresivnu aktivnost protiv više od nekoliko stotina kliničkih izolata Escherichia coli, Klebsiella pneumoniae i Acinetobacter baumannii.
Fabimicin je takođe pokazao uski opseg minimalnih inhibitornih koncentracija (MIC) među svim kliničkim izolatima. Fabimicin je takođe pokazao opseg minimalnih inhibitornih koncentracija (MIC) u poređenju sa drugim testiranim kliničkim izolatima. MIC je najniža koncentracija antibiotika koji inhibira rast bakterija.
Ovaj rezultat je ohrabrio autore "jer sugeriše da intrinzična rezistencija na fabimicin nije preovlađujuća u postojećim bakterijskim populacijama".
Otkriće sugeriše da bi fabimicin mogao biti manje štetan za crevnu mikrofloru od tipičnih antibiotika širokog spektra.
Novi lek pokazao efikasnost u eksperimentu na miševima
Nakon uspostavljanja efikasne doze fabimicina kod miševa, istraživači su procenili efikasnost fabimicina kod miševa inficiranih izazovnim sojem Escherichia coli otpornim na lekove. Ova bakterija izaziva ogromnu većinu UTI.
Primenom fabimicina intravenozno tri puta dnevno, naučnici su uspeli da smanje količinu bakterija otpornih na lekove u tkivima slezine, bešike, jetre i bubrega miševa na nivoe pre infekcije ili niže.
U svom radu, istraživači su primetili da nije postojala nova klasa antibiotika koje je FDA odobrila za lečenje gram-negativnih patogena više od pola veka, stavljajući otkriće fabimicina u perspektivu.
Upotreba fabimicina kod ljudi
Visoka moć fabimicina protiv gram-negativnih kliničkih izolata, niska učestalost bakterijske rezistencije i efikasnost u modelima infekcije miševa, mogli bi da ukaži na mogućnost i njegovu efikasnu primenu kod ljudi.
Uspešna sintetička strategija predstavljena u ovoj studiji pruža dokaze da se postojeći antibiotici efikasni protiv gram-pozitivnih bakterija mogu modifikovati da prodru i ubiju Gram-negativne bakterije.
Dr. William M. Wuest, istaknuti istraživač saveza za istraživanje Džordžije i profesor hemije na Univerzitetu Emori, izrazio je entuzijazam za rad i njegov potencijal da se prevede u efikasan tretman za tvrdoglave gram-negativne infekcije. Međutim, on je istakao da su „potrebna značajna finansijska ulaganja da bi se to dogodilo, a istorijski je to bio izazov na polju antibiotika“.
- Nama su preko potrebni novi antibiotici koji ciljaju na nove bakterijske procese i rad Hergenrother grupe identifikuje jedno takvo jedinjenje - rekao je dr Wuest.
On je dodao da su novi rezulatati do kojih se došlo "uzbudljivi i imaju potencijal da budu primenjeni u kliničkom lečenju uz odgovarajuću finansijsku podršku zajednice."
Na pitanje kako će ovo istraživanje napredovati, dr Hergenroter je rekao da je sledeći korak je rad sa odgovarajućim komercijalnim partnerom na studijama koje omogućavaju IND kao deo unapređenja ove tehnologije u kliničkom lečenju.
eKlinika zadržava sva prava nad sadržajem. Za preuzimanje sadržaja pogledajte uputstva na stranici Uslovi korišćenja.


